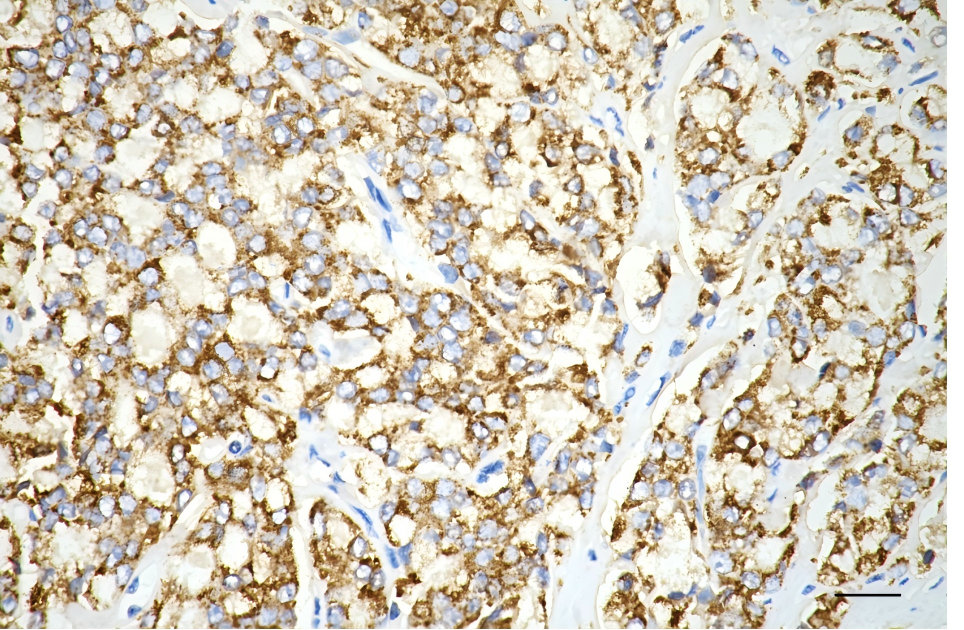

ARG2 Recombinant Monoclonal Antibody
-
中文名稱:ARG2 Recombinant Monoclonal Antibody
-
貨號:CSB-RA143188A0HU
-
規(guī)格:¥1320
-
圖片:
-
Flow cytometric analysis of Arg2 expression in HT-1080 cells using Arg2 antibody. Green, isotype control; red, Arg2.
-
Immunocytochemical staining of HT-1080 cells with Arg2 antibody. Nuclei were stained blue with DAPI; Arg2 was stained magenta with Alexa Fluor? 647. Images were taken using Leica stellaris 5. Protein abundance based on laser Intensity and smart gain: Medium. Scale bar, 20 μm.
-
Immunohistochemistry was performed on paraffin-embedded human prostatic adenocarcinoma using arg2 antibody. Antigen retrieval was done in sodium citrate buffer (pH 6.0). DAB was used for detection, with hematoxylin counterstaining. Images were acquired using a Nikon Ci-L Plus microscope (40× objective). Scale bar: 25 μm.
-
Immunohistochemistry was performed on paraffin-embedded mouse kidney using arg2 antibody. Antigen retrieval was done in sodium citrate buffer (pH 6.0). DAB was used for detection, with hematoxylin counterstaining. Images were acquired using a Nikon Ci-L Plus microscope (40× objective). Scale bar: 25 μm.
-
Western blotting analysis using arg2 antibody. Total cell lysates (30 μg) from various cell lines were loaded and separated by SDS-PAGE. The blot was incubated with arg2 antibody and HRP-conjugated goat anti-rabbit secondary antibody respectively.
-
-
其他:
產(chǎn)品詳情
-
Uniprot No.:
-
基因名:
-
別名:ARG2; Arginase 2; Arginase-2, Mitochondrial; Kidney-Type Arginase; Non-Hepatic Arginase; Arginase, Type II; Type II Arginase; Arginase II; EC 3.5.3.1; L-Arginine Amidinohydrolase; L-Arginine Ureahydrolase; Nonhepatic Arginase; Kidney Arginase; EC 3.5.3
-
反應(yīng)種屬:Human, Rat
-
免疫原:Recombinant Human ARG2 protein
-
免疫原種屬:Homo sapiens (Human)
-
標(biāo)記方式:Non-conjugated
-
克隆類型:Monoclonal
-
抗體亞型:Rabbit IgG
-
純化方式:Affinity-chromatography
-
克隆號:13D2
-
濃度:It differs from different batches. Please contact us to confirm it.
-
保存緩沖液:Rabbit IgG in PBS (pH 7.4) containing 50% glycerol, and 0.02% sodium azide.
-
產(chǎn)品提供形式:Liquid
-
應(yīng)用范圍:ELISA, WB, FC, ICC, IHC
-
推薦稀釋比:
Application Recommended Dilution WB 1:1000-1:5000 FC 1:200-1:2000 ICC 1:100-1:1000 IHC 1:100-1:200 -
Protocols:
-
儲存條件:Upon receipt, store at -20°C or -80°C. Avoid repeated freeze.
-
貨期:Basically, we can dispatch the products out in 1-3 working days after receiving your orders. Delivery time maybe differs from different purchasing way or location, please kindly consult your local distributors for specific delivery time.
-
用途:For Research Use Only. Not for use in diagnostic or therapeutic procedures.
相關(guān)產(chǎn)品
靶點詳情
-
功能:May play a role in the regulation of extra-urea cycle arginine metabolism and also in down-regulation of nitric oxide synthesis. Extrahepatic arginase functions to regulate L-arginine bioavailability to nitric oxid synthase (NOS). Arginine metabolism is a critical regulator of innate and adaptive immune responses. Seems to be involved in negative regulation of the survival capacity of activated CD4(+) and CD8(+) T cells. May suppress inflammation-related signaling in asthmatic airway epithelium. May contribute to the immune evasion of H.pylori by restricting M1 macrophage activation and polyamine metabolism. In fetal dendritic cells may play a role in promoting immune suppression and T cell TNF-alpha production during gestation. Regulates RPS6KB1 signaling, which promotes endothelial cell senescence and inflammation and implicates NOS3/eNOS dysfunction. Can inhibit endothelial autophagy independently of its enzymatic activity implicating mTORC2 signaling. Involved in vascular smooth muscle cell senescence and apoptosis independently of its enzymatic activity. Since NOS is found in the penile corpus cavernosum smooth muscle, the clitoral corpus cavernosum and the vagina, arginase-2 plays a role in both male and female sexual arousal.
-
基因功能參考文獻:
- xpression profiles revealed miR-1299 downregulation concomitant with arginase-2 (ARG2) upregulation in hyperpigmented skin of melasma patients. PMID: 28627081
- ARG2 promotes tumorigenesis, and HCMV may contribute to GBM pathogenesis by upregulating ARG2. PMID: 27363017
- fetal dendritic cells promote prenatal T-cell immune suppression through arginase-2; results reveal a previously unappreciated role of dendritic cells within the developing fetus and indicate that they mediate homeostatic immune-suppressive responses during gestation PMID: 28614294
- Schizophrenia patients had increased arginase II protein expression in the frontal cortex compared to controls. PMID: 27529679
- our data provide compelling evidence that human cytomegalovirus reduced the level of microRNA-613 which functions as an anti-onco-miRNA in glioblastoma, primarily by downregulating the expression of arginase-2 PMID: 28718378
- overexpression of AMPK induced arginase II protein expression and viable cells numbers in human Pulmonary artery smooth muscle cell . PMID: 28213467
- Data show that transfection with Arginase II-small interfering RNA prevented hypoxia-induced cell proliferation. PMID: 27475813
- circulating Arginase 2 concentrations increase in clinical erectile dysfunction (ED) and are associated with increased risk for ED PMID: 26537638
- arginase 2 impairs endothelial autophagy independently of the L-arginine ureahydrolase activity through activation of RPS6KB1 and inhibition of PRKAA, which is implicated in atherogenesis PMID: 25484082
- High arginase II expression correlates with poor survival for patients with neuroblastoma. Neuroblastoma suppresses T-cell proliferation via arginase II expression and activity. PMID: 26054597
- high fat diet enhanced arginase-II expression/activity and p38mapk activity, which was associated with eNOS-uncoupling as revealed by decreased nitric oxide PMID: 25034973
- Arg-II, p38, and S6K1 form a positive circuit which regulates endothelial senescence and cardiovascular aging. PMID: 25635535
- OxLDL triggers retrograde translocation of arginase2 in aortic endothelial cells via ROCK and mitochondrial processing peptidase. PMID: 24903103
- These results demonstrate that S6K1 and arginase-II form a positive circuit mediating the detrimental effects of chronic L-arginine supplementation on endothelial cells. PMID: 24860943
- We speculate that cytomegalovirus may contribute to endothelial dysfunction via ARG II induction and reduced eNOS production. PMID: 24442486
- study identified arginase II as a new target of miR-17-5p in human pulmonary artery smooth muscle cells (hPASMC), with miR-17-5p involved in the hypoxic induction of arginase II in hPASMC; also found evidence supporting a feedback loop between arginase II and miR-17-5p, such that arginase II regulates miR-17-5p expression in hPASMC PMID: 24879052
- Data indicate that arginase II (Arg II) expressions were higher in breast tumor tissues compared to the matched normal. PMID: 24223914
- HDAC2 is a critical regulator of Arg2 expression and thereby endothelial nitric oxide and endothelial function. PMID: 24833798
- Arg-II promotes mitochondrial dysfunction leading to VSMC senescence/apoptosis through complex positive crosstalk among S6K1-JNK, ERK, p66Shc, and p53, contributing to atherosclerotic vulnerability phenotype. PMID: 23832324
- Maternal hypercholesterolemia in pregnancy alters umbilical vein reactivity because of fetal endothelial dysfunction associated with arginase and eNOS signaling imbalance. PMID: 23950140
- Gene expression studies have identified altered expression of arginase 2 in suicide completers with a history of mood disorders. PMID: 23260169
- presence of ARG2-expressing CAFs is an indicator of poor prognosis, as well as hypoxia, in pancreatic ductal carcinoma PMID: 23424623
- Endothelial eNOS/arginase imbalance contributes to vascular dysfunction in IUGR umbilical and placental vessels. PMID: 23122700
- arginase-II (ARG2) was expressed by 60 percent of head and neck squamous cell carcinomas; the absence of ARG2 expression was significantly associated with prolonged overall survival PMID: 22815199
- The inhibition of arginase II protein was found to be mediated by exchange protein directly activated by cAMP. PMID: 22447968
- This study demomistrated that H3K4me3 modification plays an important role in up regulation of ARG2 in prefrontal cortex. PMID: 22008221
- Data suggest that exposure to particulate matter (i.e., air pollutants) upregulates arginase II (but not arginase I) activity and expression in bronchial epithelial cells, in part, via epidermal growth factor-dependent signaling. PMID: 22712848
- DDIT3, STT3A, ARG2 and FAM129A immunohistochemistry does not appear to be useful in the diagnosis of thyroid follicular neoplasias, as they do not reliably distinguish follicular thyroid carcinoma from follicular thyroid adenoma. PMID: 22157935
- has a vascular role in placental vessels counteracting the NOS-dependent relaxation PMID: 22391327
- Sequence variations in the NOS2A and ARG2 loci were globally associated with exhaled nitric oxide PMID: 21039601
- Delineate a clearer path from OxLDL through the endothelial cell LOX-1 receptor, RhoA, and ROCK, to the activation of arginase II, downregulation of NO, and vascular dysfunction in atherosclerosis. PMID: 21130456
- gene silencing changed promotes apoptosis and reduced expression of cell proliferation markers in thyroid cancer cells PMID: 20542107
- In human lung microvascular endothelial cells, hypoxia upregulates arginase activity as well as mRNA and protein levels of arginase II. Inhibition of arginase II by small interfering RNA or by the inhibitor BEC enhanced NO levels. PMID: 20861464
- The alteration of arginase activity between colostrum and mature milk may be a consequence of the transfer of arginase from the blood of the breast mother mammary glands into the colostrum and mature milk PMID: 20853600
- Arginase contributes significantly to L-proline supply for collagen synthesis in rat fibroblasts, in which arginase I is the predominant isoenzyme, but not in human fibroblasts, in which arginase II is the only isoenzyme expressed PMID: 20107769
- Association of ARG2 gene polymorphism is present in adult asthma, has lower reversibility specific with beta2 agonists. It is also associated with asthma severity, severe airway hyperresponsiveness, and less long-term response to inhaled corticosteroids. PMID: 20124949
- There was an overexpression of arginase II in anorexia nervosa patients. PMID: 20071203
- [Review] Arginase is constitutively expressed in endothelial cells, but expression of the specific isoforms differs among mammalian species. Although some arginase I has been detected in human endothelial cells, the predominant isoform is arginase II. PMID: 19508396
- Plays a physiological role in male and female sexual arousal PMID: 12859189
- Increased arginase II expression and activity in pulmonary arterial hypertension. PMID: 15364894
- ArgII gene is an early IRF-3-regulated gene, which participates in the interferon-independent antiviral response through polyamine production and induction of apoptosis. PMID: 15955070
- The Asn149-->Asp mutation is proposed to generate a conformational change responsible for the altered substrate specificity of arginase II. PMID: 16128822
- Increasing L-Arg for NO synthesis by either arginase inhibition or direct L-Arg supplementation restores the age-related deficit in reflex cutaneous vasodilatation. PMID: 16675494
- observed in both cytotrophoblasts and syncytiotrophoblasts PMID: 16720041
- Increased arginase II expression & activity suggest a potential pathogenic role for platelet arginase and altered arginine and polyamine metabolism in sickle cell disease. PMID: 17353439
- arginase II expression may play a role in prostate cancer progression PMID: 18202758
- Cocoa flavonols lower ARG2 activity in endothelial cells in vitro and erythrocytes in vov. PMID: 18348861
- ARG2 is expressed in lung cancer, but it does not induce tumor immune escape and does not affect disease progression, most probably due to the lack of concomitant NOS expression. PMID: 18528866
- siRNA silencing of arginase-II but did not inhibit the up-regulation of endothelial VCAM-1, ICAM-1 and E-selectin by TNFalpha PMID: 19284655
顯示更多
收起更多
-
亞細胞定位:Mitochondrion.
-
蛋白家族:Arginase family
-
組織特異性:Expressed most strongly in kidney and prostate, much less strongly in the brain, skeletal muscle, placenta, lung, mammary gland, macrophage, uterus, testis and gut, but apparently not in the liver, heart and pancreas. Expressed in activated T cells.
-
數(shù)據(jù)庫鏈接:
Most popular with customers
-
YWHAB Recombinant Monoclonal Antibody
Applications: ELISA, WB, IHC, IF, FC
Species Reactivity: Human, Mouse, Rat
-
Phospho-YAP1 (S127) Recombinant Monoclonal Antibody
Applications: ELISA, WB, IHC
Species Reactivity: Human
-
-
-
-
-
-